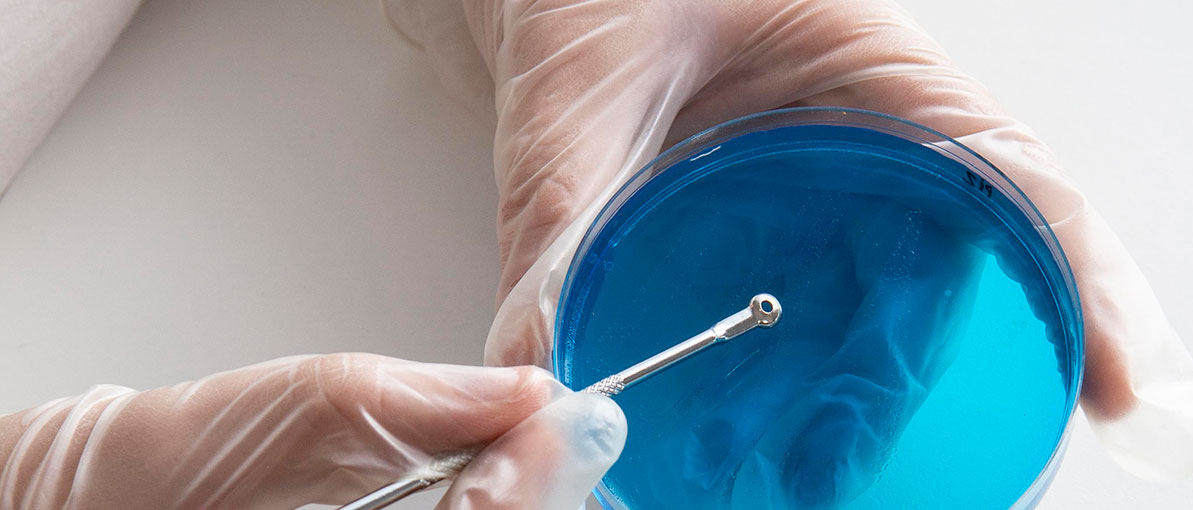

Sampling and Analysis of Mold
The next step in the inspection process is to take samples and send the samples to the laboratory to analyze and identify what specific type of mold is on the property and how many spores are in the air.
Professional mold tests serve several purposes. One of the most common reasons people decide to test for mold is lingering odor and visible discoloration on walls and other surfaces. Others experience sudden symptoms like coughing, sneezing, and headaches.
Visible mold indicates a 100% probability of mold spores and airborne mycotoxins (toxic substances produced by fungi (called mycotoxigenic fungi) in the various substrates where they grow. Mycotoxins can be toxic when inhaled, absorbed through the skin, or consumed through food).
If visible mold is observed, a comprehensive mold remediation program should be initiated as soon as practical. When there is no visible mold, but the odor of mold or mycotoxins is noticeable, a mold inspection and indoor air quality test can reveal if and where mold is elevated.
Reasons to do an air and surface sampling analysis:
Testing your property for mold will give you important information about the health of your indoor environment. You will:


• Confirm the presence of mold
• Identify the types of mold present (including black mold)
• Locate sources of moisture
• Assess the extent of contamination
• Assess health risks
• Plan a mold remediation
• Provide evidence for insurance claims/litigation
• Pass cleaning tests (to verify completion of work)
Our mold inspection company in Miami, Florida uses state-of-the-art technology such as thermal imaging cameras and moisture meters to find the best places to test. Our inspectors then collect air/surface samples to determine which mold species are present in your air. This is the only accurate way to determine what is happening to your indoor air quality. So rest easy Miami Florida resident, if there is a problem with mold growth in your home or business, Miami Mold Expert inspectors will find the problem and identify the source. When it comes to mold, testing is the only method that can give you the answers you need.